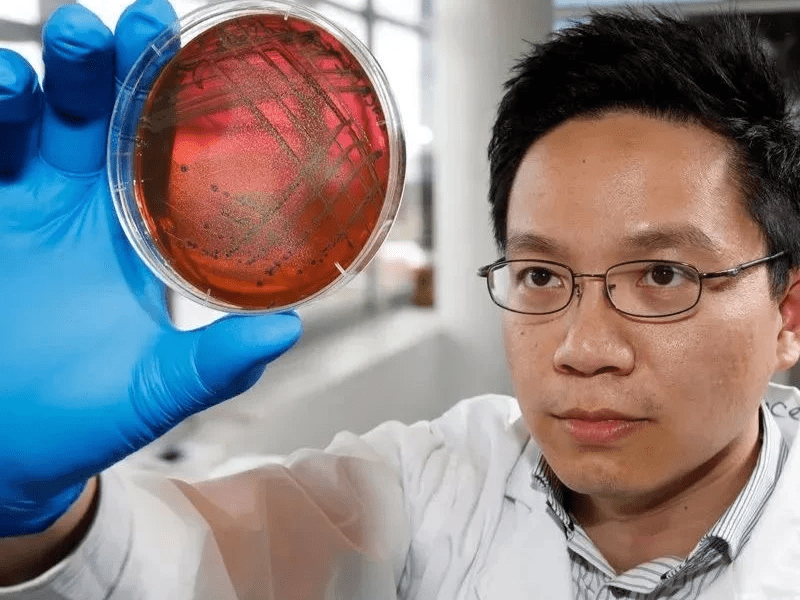
Section image

University of Tasmania
澳洲塔斯馬尼亞大學
AMC澳洲海事學院全球產業排名第一
2023泰晤士全球大學影響力-氣候行動排名第一
學校資訊
- CRICOS:00586B
- 創校時間:1890
- 學校類型:公立大學
- 所在城市:霍巴特, 塔斯馬尼亞
- 學生人數:約20,000人
- 國際生比:21%
- 教學制度:學期制
- 學校官網:https://www.utas.edu.au/
塔斯馬尼亞大學成立於1890年,是澳洲歷史第四悠久的大學。校區包含霍巴特、朗塞斯頓、紐漢姆,並利用本州最好的自然和人工資源提供高質量的教育和研究。課程得到了澳洲國內及海外相關行業及專業團體的認證和專業認可。學生人數包括了來自100多個國家的7000多名國際學生。
塔斯馬尼亞大學多種多樣的學位、海外交流和學習經歷,能為學生提供獨特的教育體驗,為未來的職業生涯做足良好的準備。學校提供100多個學學位,以及包括從研究生證書到研究所高等學位在內的150多個研究生項目,包括了建築學、海事和農業等領域的學位。
作為塔斯馬尼亞州唯一的一所大學,塔斯馬尼亞大學深知課堂外的學習和生活同樣重要。如果你喜歡藝術和文化、美食和葡萄酒、喜歡探索戶外大自然,塔斯馬尼亞充滿了在其他任何地方都找不到的體驗。塔斯馬尼亞大學的學生體驗不僅僅是學習,更是在課堂之外創造難忘的生活體驗。在這裡求學是人生樂事。
為什麼選擇塔斯馬尼亞大學?

歷史悠久
塔斯馬尼亞大學成立於1890年,至今已經有超過133年歷史,是澳洲第四古老的大學。
優質的教學
2023世界大學排名第293,其中地球與海洋科學、地球物理學、地質學位列於全球前100。
獎學金豐厚
多種提供給國際留學生的獎學金,不僅有25%學費減免的TIS塔斯馬尼亞國際獎學金,還有免費語言課程的獎學金機會,為國際學生的學習和生活提供強而有力的支援!
實習機會與就業幫助多
塔斯馬尼亞大學提供各種各樣的實習機會,每個專業都有實習機會可以申請,包含商科、IT、工程、傳媒等專業。教學、社工、醫藥學、護理等專業也都自帶實習。此外,還有永續發展實習專案供學生選擇,國際學生可於在學階段就累積永續發展的實踐經驗。
在校期間,學生將獲得各種就業指導和幫助,2022/23 The Good Universities Guide 塔斯馬尼亞碩士研究生就業率全澳第一,2023 QILT 報告塔大學士畢業就業工資中位數為全澳第一。
平易近人的留學費用
塔大留學費用較低,大部分的學位課程學費在3-3.7萬澳幣之間,更有多項獎學金可申請。同時塔斯馬尼亞的生活成本低於澳洲其他都市,可再更節約留學費用。
小班教學制度
塔大採用小班授課,學生和老師的交流機會多,注重學生的個性化培養,學生可以隨時向講師和輔導員尋求幫助或支援。

🏆 排名及榮譽
✅ 2023 泰晤士全球大學影響力-氣候行動排名第一
✅ 全球學術排名前2%大學
✅ 2023 QS 全球大學排名293
✅ IMAS 海洋與南極研究學院全澳第一
✅ 碩士就業率全澳第一、學士就業薪資中位數全澳第一
✅ AMC澳洲海事學院全球排名第一
✅ 澳洲六所工業4.0實驗室之一
✅ 商學院獲得AACSB認證,列於全球前5%
✅ 澳洲人機互動實驗室HIT Lab Australia所在地
頂尖課程 🧑🎓

海洋與南極科學
Marine and Antarctic Science
UTAS海洋學排名全球第11,澳洲第一。塔大開設全球唯一專注於南極的海洋科學碩士學位,同學們將在世界及教育研究中心IMAS學習,擁有使用12個專項實驗室中頂尖器材的機會,塔大還與澳洲南極局、聯邦科學與工業研究組織等權威機構合作,讓學生們有機會提前收穫真正工作經驗。

科學
Science
大氣科學、生態學排名全球第51-75名。地球科學排名全球前100名。塔大擁有許多一流科學實驗室,參與了SpaceX、NASA等國際知名產業夥伴的重要專案。塔州得天獨厚的地理優勢也讓學習生態學及地球科學學生擁有大量實地考察機會。同學們可在天然實驗室裡快速成長。

農業
Agriculture
農業學排名全球前100。塔大學生可以在TIA農業研究所中接觸到最新產業動態和一線學術研究,成為前景無限的農業人才。TIA也位同學創造許多實習機會。TIA不僅在塔州擁有四個自營農場,讓同學們可以實地接觸乳製品、蔬菜及穀物等作物,還和產業夥伴合作,透過實地考察、實習,豐富同學學習經歷。在氣候多變、農業挑戰加劇的當下,農業相關專業人士成為我們的飲食守護者,也創造了更多就業機會。

工程
Engineering
礦業工程排名全球第51-75名。塔大注重培養學生的動手實踐能力以及跨學科知識,確保同學們在畢業後能共順利適應多樣的工作環境。塔大與眾多塔州企業有密切合作,為同學帶來許多參與實習的機會,如工程榮譽學士就將完成12週實習。2023年塔大工程學院還實施“職業準備工程學位 PRIMED”將產業大佬帶進校園,使同學學習寶貴經驗、建立產業人脈。
學生宿舍
塔斯馬尼亞大學根據學生根據學生需求提供不同的學生住宿:包括學生公寓、分租公寓等多種不同房型。提供霍巴特校區及朗賽斯頓校區學生宿舍,從學校出發可步行至大部分的住所。此外,還提供學習支援、社交機會和體育活動。塔大尤其注重學生安全,在所有學生宿舍均配備全天候的保全,學生還可以透過校內APP隨時得到保全的幫助。費用根據房型及地點從澳幣$188-$410/週不等。

塔斯馬尼亞大學介紹
加入LINE官方帳號後,
請發訊息告訴我們你想諮詢的課程呦!
相關文章
Related Posts
104 台北市中山區復興北路164號4樓 (捷運南京復興站)
© Copyright 2025 OMNi Education
All Rights Reserved.